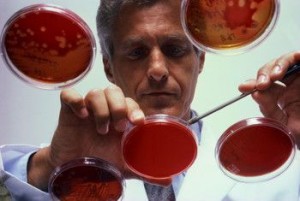
Science guy doing microbiology stuff with petri dishes.

Mold Inspectors
And Non Mold Contaminates
When mold inspectors consider possible contaminants in indoor environments most mold inspectors assume that mold spores are the problem.
Why do most people, including mold consultants and their client’s jump to the conclusion that mold spores are the cause of our health complaints after water damage occurs?
There Are Two Main Reasons:
1) We follow a simple straight forward logical path that is correct most of the time but not all of the time. Here is the logical path that we all follow. Mold formed after water damage occurred. I got sick shortly after the water damage occurred. Therefore, it must be mold spores causing illness.
2) In addition, mold spores are the easiest to sample, quantify, and identify contaminants associated with damp indoor environments. They have received much attention in our society, so mold spores are all that most of us look for or think about during a mold inspection.
The problem with this is that if a mold inspector takes samples for mold spores and finds no unusual mold spore levels, then he or she might assume that there is no problem. Legitimate complaints may be dismissed as imaginary. The home-owner gets a strange look from the inspector, and the true problem goes unresolved for several more years.
So in conclusion, your mold inspector must not overlook non-mold contamination in wet buildings. Many indoor pollutants appear in combination with mold spores. These other contaminants can be the cause of serious problems.
Institute of Medicine Study
In 2004 the Institute of Medicine did a study review titled Damp Indoor Spaces and Health. This was a very massive and important review of data and findings from many previous important scientific studies. The researches concluded that exposure to air in water damaged buildings has a direct correlation to respiratory illness. That is no surprise. What was an important and surprising find is that the exact causative agents are not always mold spores. This study that summarized many previous study findings confirmed what I have often observed during mold testing. And that is that it is quite possible for people to have health reactions to water damaged indoor environments even when the levels of mold spores are not elevated. The study also confirmed something else that we always believed, and that is that mold odors may play a role in building related illness.
Thus it is a well-established fact that exposure to air in water damaged buildings can and dose cause health issues. However, there is a complex mixture of substances with possible synergistic effects that are to blame and not just spores. The good news is that you do not need to have all these substances tested. If your building or home is water damaged or moldy mold remediation will typically take care of all the above problems in the affected areas.
To learn more about some of the specific non spore type contaminates often found in association with dampness and mold please visit the webpage that discusses the issue in more detail.
For Part 2 of this article click here and learn about some specific non mold contaminants found in water damaged buildings.